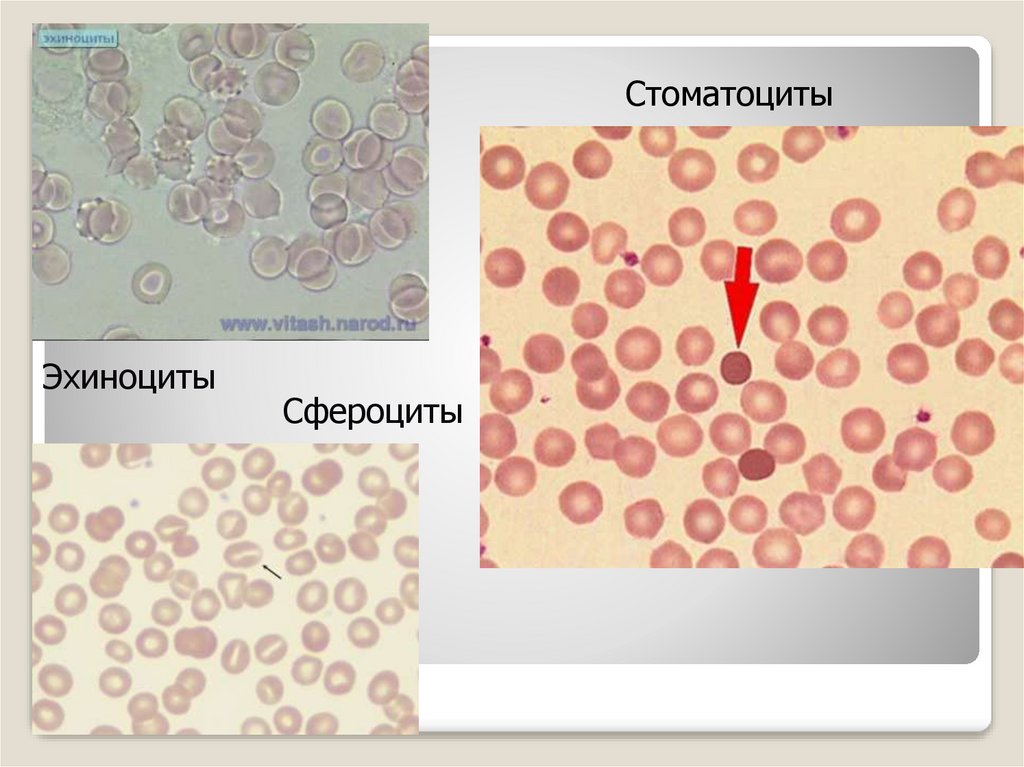
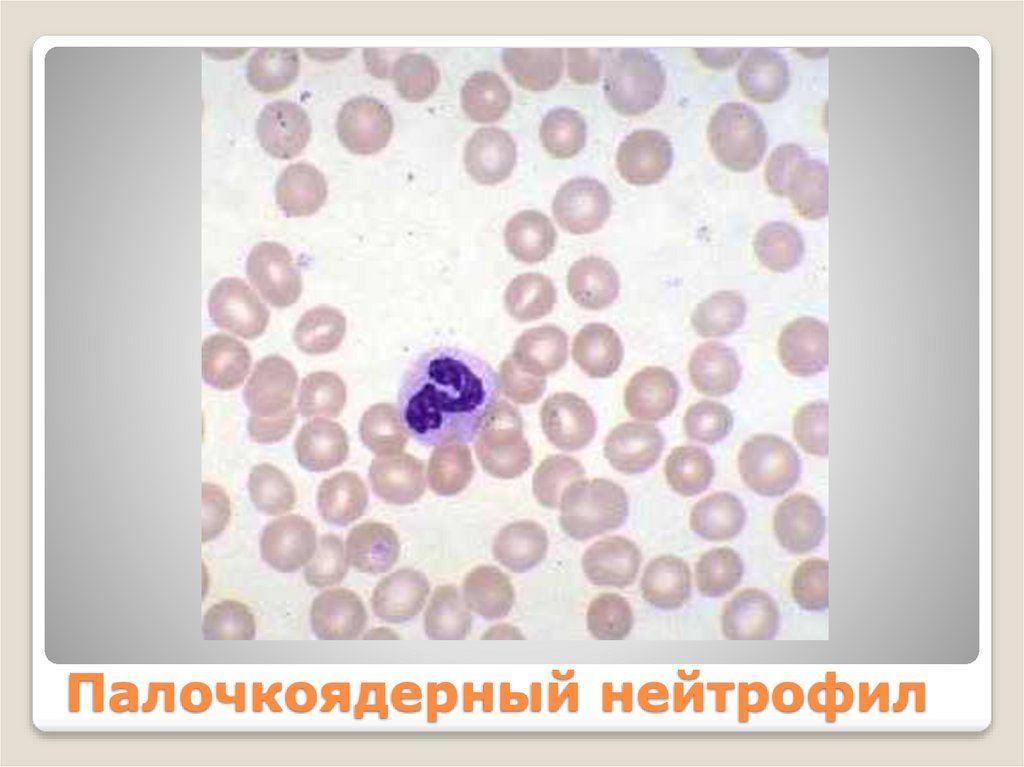
Палочкоядерный нейтрофил
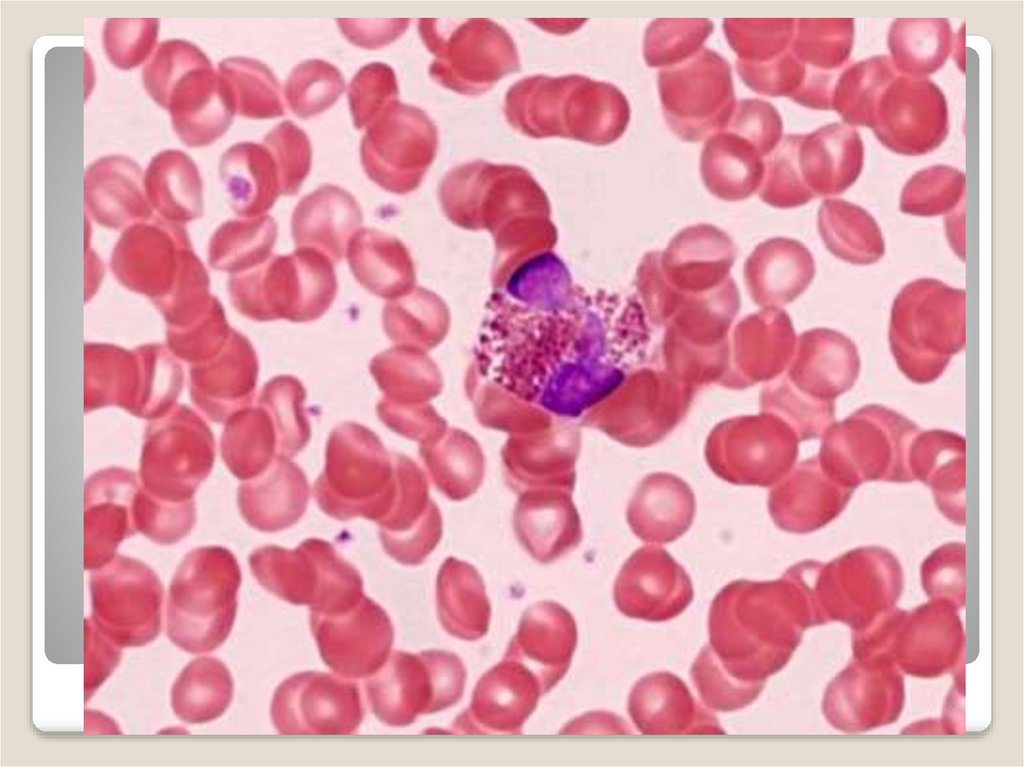
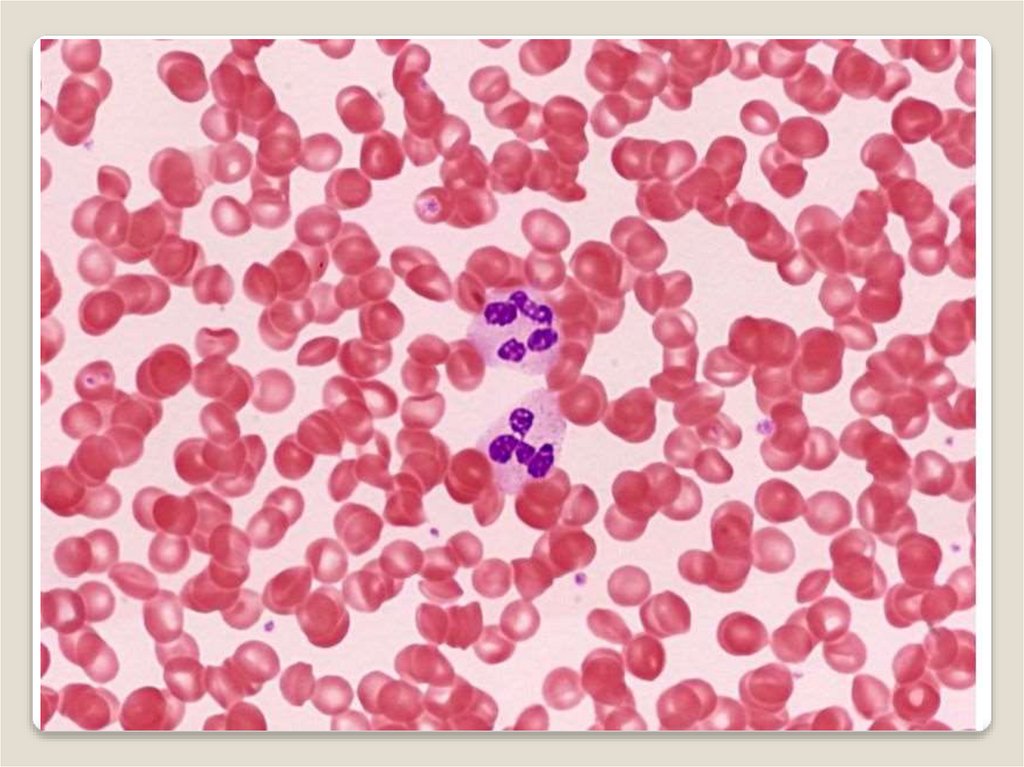
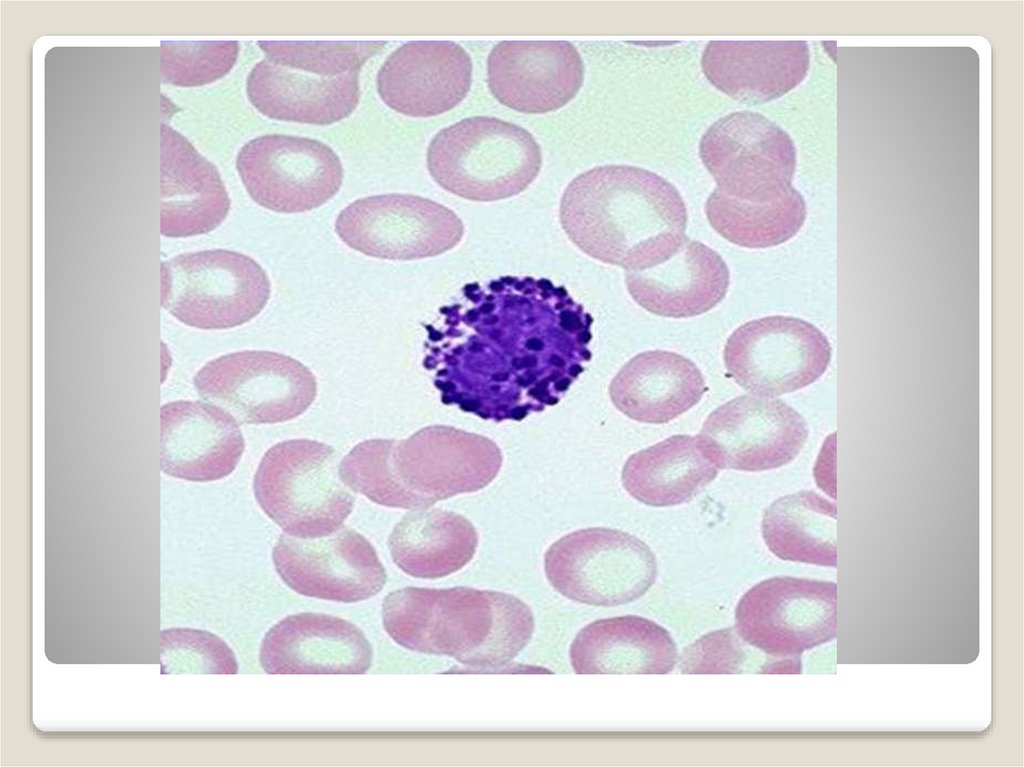
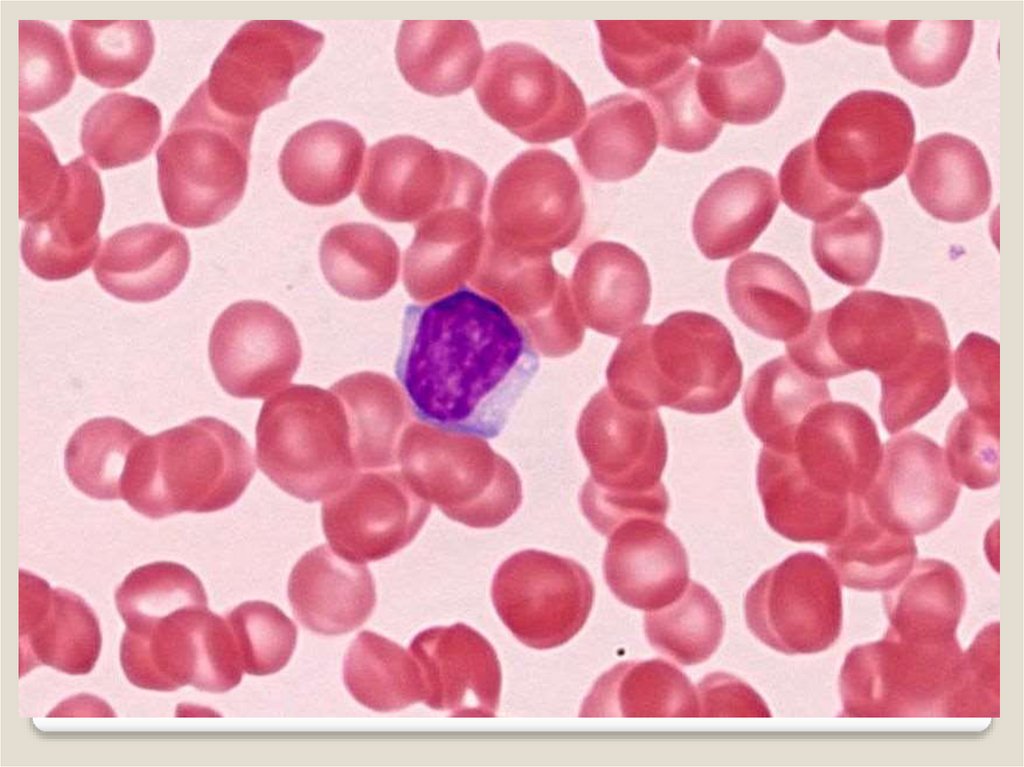
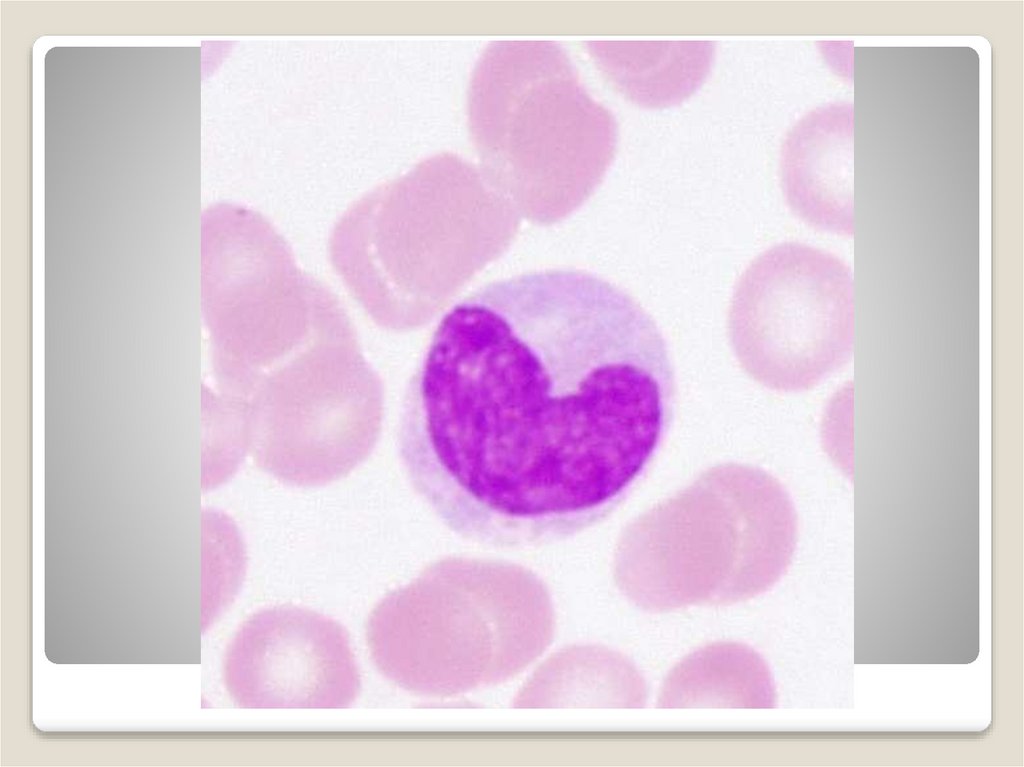
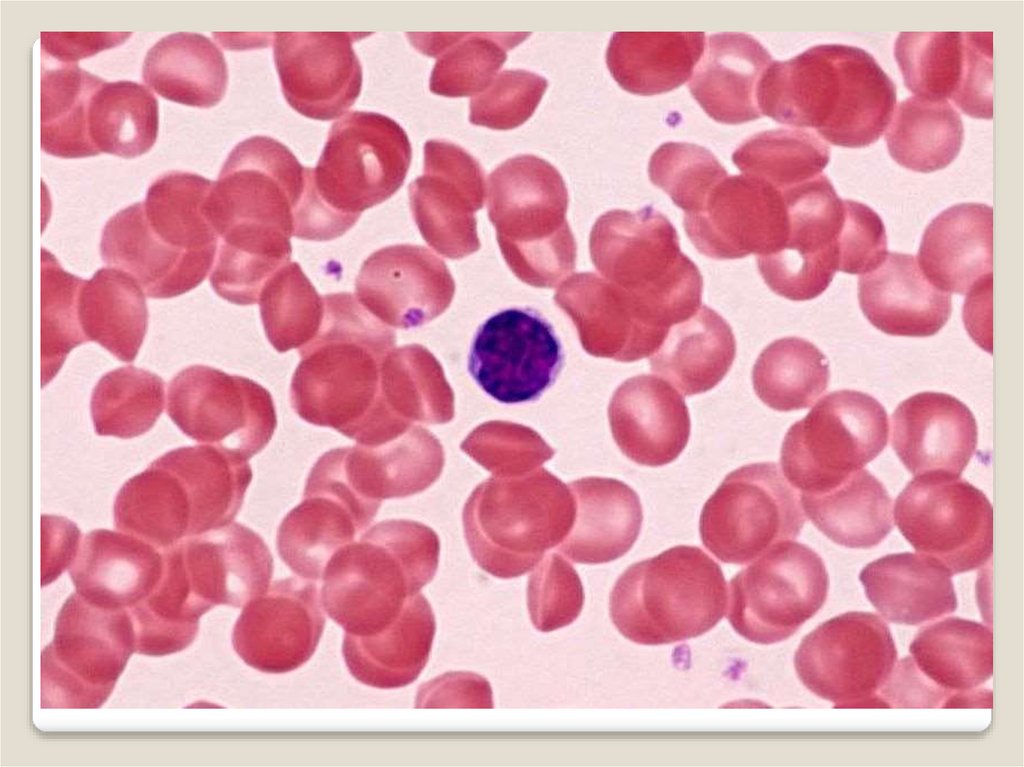

Similar presentations:
Ткани внутренней среды. Кровь. Практическое занятие
1. ФГБОУ ВО ЮУГМУ Минздрава России Кафедра гистологии, цитологии и эмбриологии
Практическое занятиеТема: Ткани внутренней среды. Кровь
2. Ткани внутренней среды организма
А)кровь и лимфаБ) соединительные ткани
В)хрящевые и костные
Ткани внутренней среды
организма
3.
4. Нормальные показатели гемограммы
Эритроциты:у мужчин – 3,9-5,5 ×1012/литр
у женщин – 3,5-4,9 ×1012/литр
Ретикулоциты – 2-15 ‰ (промилле)
Лейкоциты – 4-9 ×109/литр
Тромбоциты – 150-350 ×1012/литр
Гемоглобин:
у мужчин – 130-160 г/л
у женщин – 3,5 г/л
Цветовой показатель – 0,86-1,05 ед
Нормальные показатели
гемограммы
5. Лейкоцитарная формула – это процентное соотношение различных форм лейкоцитов к общему числу лейкоцитов
Лейкоциты – 4-9 ×109/литр (100%)Нейтрофилы – 55-75%
Юные нейтрофилы – 0-0,5 %
Палочкоядерные нейтрофилы – 2-5%
Сегментоядерные - 55-65 %
Эозинофилы – 2-5%
Базофилы – 0,5-1%
Моноциты – 5-8 %
Лимфоциты – 20-35%
В-лимфоциты – 20-25%
Т-лимфоциты – 70-75%
Лейкоцитарная формула – это процентное
соотношение различных форм лейкоцитов к
общему числу лейкоцитов
6.
Рис.: Форменныеэлементы крови
человека в мазке:
1 – эритроцит,
2 – тромбоциты
(кровяные
пластинки).
3 – сегментоядерный
нейтрофильный
гранулоцит,
4 – палочкоядерный
нейтрофильный
гранулоцит,
5 – средний лимфоцит
6 – базофильный
гранулоцит,
7 – эозинофильный
гранулоцит
8 – малый лимфоцит,
9 – моноцит
7. Эритроциты
8.
9. Красный цвет крови придает гемоглобин, содержащийся в эритроцитах.
Гемоглобин являетсясложным белком,
состоящим из белка
глобина и четырех
молекул небелковой
группы – гема. Гем имеет
в своем составе атом
железа, способный
присоединять или
отдавать молекулу
кислорода
Красный цвет крови придает
гемоглобин, содержащийся в
эритроцитах.
10.
11.
СтоматоцитыЭхиноциты
Сфероциты
12. Лейкоциты
13.
Признаки сравненияЛейкоциты
1. Форма
Форма различна. Ядерные клетки, способные к
активному
перемещению.
Подразделяются
на
гранулоциты (эозинофилы, базофилы и нейтрофилы)
и агранулоциты (лимфоциты и моноциты)
2. Место образования
Красный костный мозг, селезенка, лимфатические
узлы
3. Продолжительность
жизни
от 1 дня до нескольких лет
4.Функции
1.
2.
Защитная функция
Иммунная функция
3.
Секреция БАВ
14. Виды лейкоцитов
15. Гранулоцит
Размеры гранулоцитов таковы:нейтрофилы – 8-10 мкм, базофилы – 810 мкм, эозинофилы – 10-12мкм.
При это гранулоциты имеют два
характерных признака:
-специфическую зернистость в
цитоплазме(чем и обусловлено их
название);
-а также обычно сегментированное ядро.
Гранулоцит

medicine
medicine








